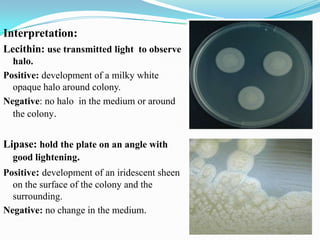
Interpretation:
Lecithin: use transmitted light to observe
halo.
Positive: development of a milky white
opaque halo around colony.
Negative: no halo in the medium or around
the colony.

Lipase: hold the plate on an angle with
good lightening.
Positive: development of an iridescent sheen
on the surface of the colony and the
surrounding.
Negative: no change in the medium.

The document provides information on various biochemical tests performed to identify bacteria, beginning with tests for enzymes. It describes the catalase test in detail, including the principle, reagents, controls, and methods. It notes that catalase is present in most aerobic and facultative anaerobic bacteria except streptococcus species. The document then briefly summarizes several other enzyme tests including oxidase, urease, ONPG, and nitrate reduction. It concludes by stating the order of typical biochemical tests is first enzymes, then tests for specific breakdown products, ability to utilize substances, and metabolism of carbohydrates, proteins and amino acids.